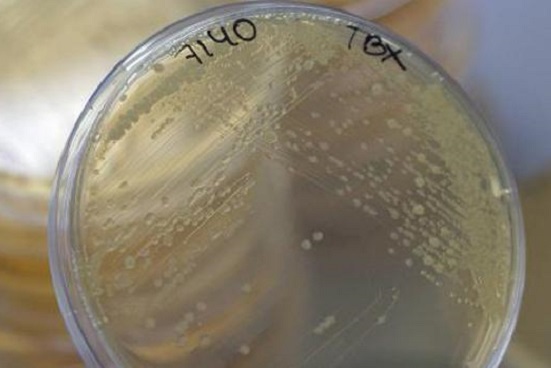

Un grupo de científicos de la Universidad de Pensilvania, en Estados Unidos, desarrolló un dispositivo que permite capturar e identificar varias cepas de virus en sólo unos minutos, informó un estudio publicado en la revista Proceedings.
En la actualidad se estima que existen cerca de dos millones de virus en animales, algunos de los cuales pueden transmitirse a los humanos.
«Hemos desarrollado un dispositivo portátil rápido y económico que puede capturar los virus según el tamaño», dijo mediante un comunicado el responsable de la investigación y profesor de esa universidad, Mauricio Terrones.
El dispositivo, denominado Virrion, utiliza matrices de estructuras cilíndricas de carbono que están diseñadas para capturar diferentes virus de acuerdo con su tamaño y que puedan ser detectados en el lugar a través de la técnica espectroscopía Raman.
«Agregamos nanopartículas de oro para mejorar la señal Raman y se puedan detectar las moléculas de los virus en concentraciones muy bajas. Luego usamos técnicas de aprendizaje automático para crear una biblioteca de tipos de virus».
Esta innovación puede ser utilizada tanto para la detección temprana de virus en humanos como en animales y dentro del campo. Incluso por su tamaño y costo puede ser útil dentro de consultorios médicos y poblados lejanos cuando se producen brotes de enfermedades, mencionaron los autores.
Los científicos señalaron que esperan usar este dispositivo para capturar y secuenciar la unidad estructural de los virus, lo que permitirá un mejor manejo de la evolución de estos en tiempo real.
Fuente: NTX